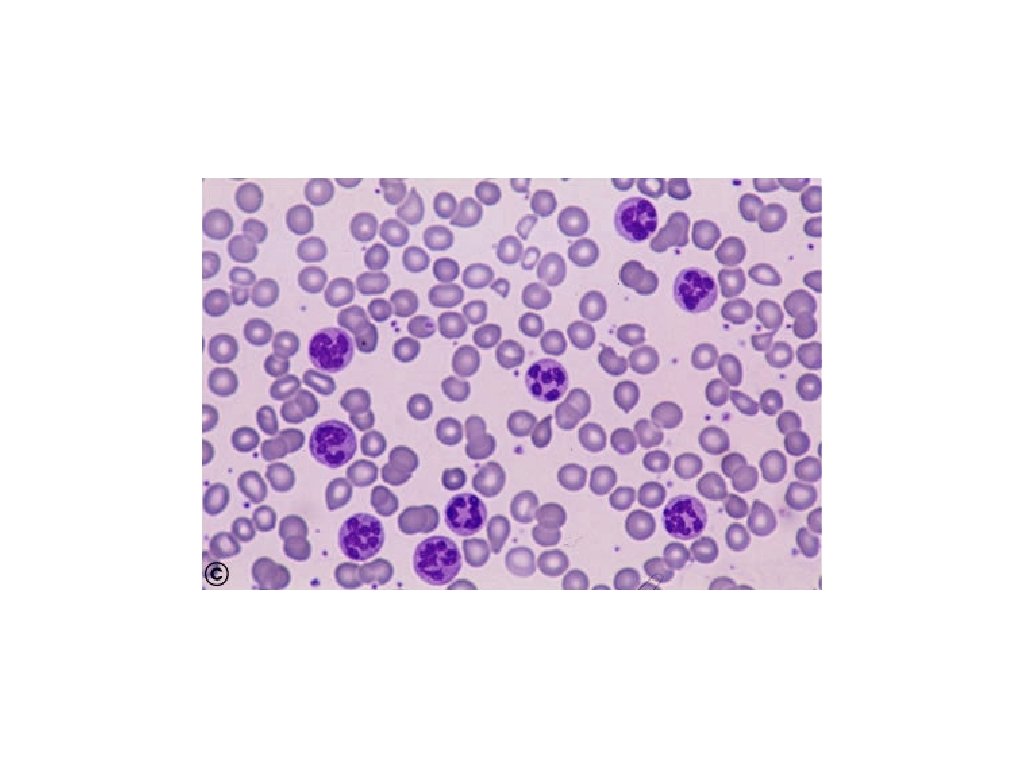
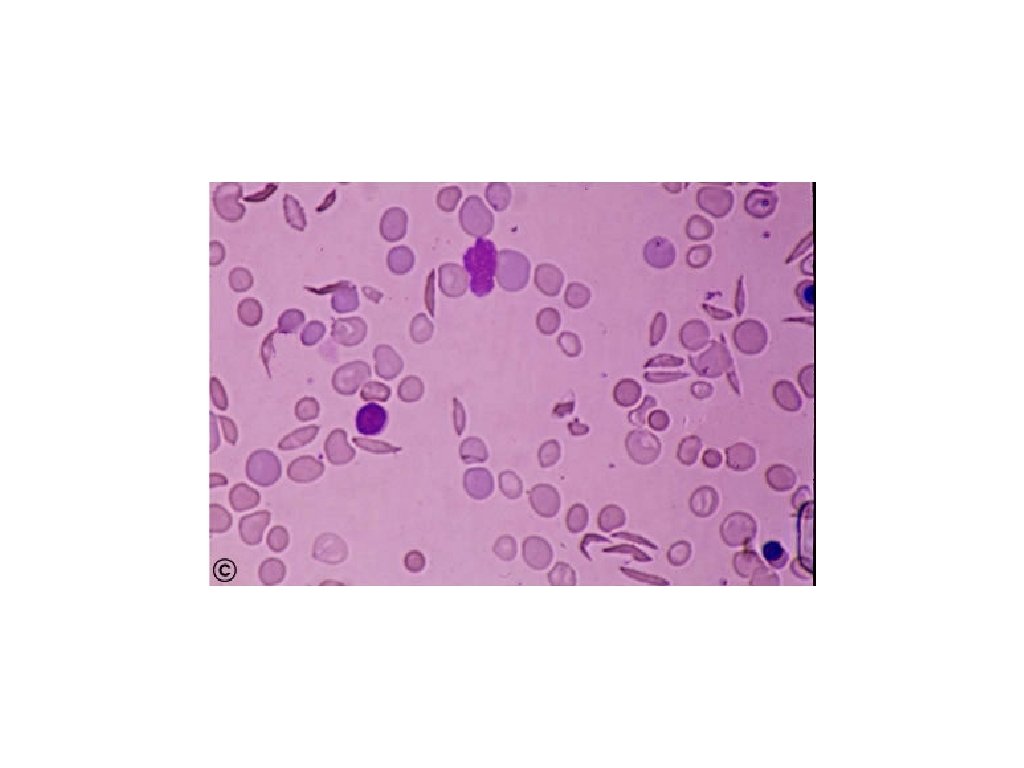

Anemia CBC retic count Hypoproliferative Retics normal or

Anemia CBC, retic count Hypoproliferative Retics normal or increased

Hypoproliferative Clues from morphology microcytic, normocytic, or macrocytic poikilocytosis Marrow damage > Infiltration; fibrosis > Aplasia > Myelodysplasia > Drug or radiation injury Iron deficiency anisocytosis B 12 deficiency nucleated red cells Folate deficiency target cells Howell-Jolly bodies hypersegmented polys Stimulus > Inflammation > Endocrine defect > Renal disease Hypersplenism

Retics normal or increased Hemorrhage and Hemolysis Clues from morphology Blood loss red cell fragmentation Hemolysis > Antibody-mediated > Membrane defect > Metabolic defect > Red cell fragmentation red cell clumping Hemoglobinopathy microcytic, normocytic, or macrocytic nucleated red cells target cells

IRF = immature reticulocyte fraction = immature retics / total retics HLR% = high light scatter retics = Retics% x IRF Foucade, Belaouni. Lab Hematol 1999; 5: 153 -8

IRF and Anemia Foucade, Belaouni. Lab Hematol 1999; 5: 153 -8




Direct anti-globulin test

Regulation of iron absorption Gut lumen +++ Fe Enterocyte Ferritin Enterocyte precursor Transferrin Receptor HFE Hepcidin ++ Fe Heme Fe DMT 1 ++ +++ Fe Fe MTP 1 Plasma transferrin

Iron stores Erythron iron • Marrow iron • 1 - 3+ • 0 - 1+ • 0 • Ferritin • 50 - 200 • <20 • <15 • 0 • TIBC • 300 - 360 • >380 • >400 stores • Serum iron • 50 - 150 • <50 • <30 • Red cells • normal • microcytic, • normal hypochromic


Gastrointestinal absorption 1 mg/day Storage iron Liver, RES 1 gram Plasma transferrin 2 mg Daily physiologic loss 1 mg Functional iron Blood, marrow, myoglobin 2 grams

Serum iron after oral iron in patients with iron deficiency Serum iron 80 60 40 20 1 2 3 4 Hours WH Crosby, Arch Int Med; circa 1970

Serum ferritin and total body iron Kaltwasser, Gottschalk. Kidney Int. 1999; 55(suppl): S 49 - S 56

Serum transferrin receptor Storage iron = 107 mg Storage iron = 335 mg Storage iron = 1, 102 mg Serial measurement of s. Tfr during phlebotomy in 3 individuals Goodnough, Skikne, Brugnara. Blood, 2000; 96: 823 - 833

Ratio of serum transferrin receptor to ferritin as a measure of total body iron Cook, Flowers, Skikne. Blood 2003; 101: 3359 - 64

Erythropoietin response in iron deficiency Spivak JL. Lancet 2000; 355: 1707 - 12

Serum erthyropoietin levels in patients with inflammatory bowel disease Controls = normal volunteers and patients with traumatic blood loss Schreiber, Howalt, et at. NEJM 1996; 334: 619 - 23

IL-1 and anemia in patients with inflammatory bowel disease Schreiber, Howalt, et at. NEJM 1996; 334: 619 - 23

Treatment with oral iron ± r. EPO in patients with inflammatory bowel disease Schreiber, Howalt, et at. NEJM 1996; 334: 619 - 23

Anemia of chronic disease Inflammation Tissue necrosis Infection Neoplasia Congestive heart failure Acute myocardial infarction

Anemia of chronic disease Typical lab findings: Serum iron < 50 TIBC < 150 Normochromic or hypochromic red cells Normal ferritin Normal serum transferrin receptor

Anemia of chronic disease Mechanisms: blunted erythropoietin response diminished response of erythroid precursors to erythropoietin decreased delivery of iron from RES, increased intracellular ferritin in macrophages decreased gastrointestinal iron absorption

Anemia of chronic disease Mediators: IL-1 IL-6 g-interferon TNF-a

Mortality and initial hematocrit in PRAISE Prospective randomized amlodipine survival evaluation 1130 patients 15 month follow-up Results adjusted using multivariant Cox model for age, gender, diabetes, smoking, heart failure etiology, EF, NYHA class, systolic BP, WBC, creatinine, and 18 additional factors Mozaffarian, Levy, et al. J Am Coll Cardiol 2003; 41(11): 1933 - 9

Mortality and initial hematocrit in PRAISE Mozaffarian, Levy, et al. J Am Coll Cardiol 2003; 41(11): 1933 - 9

Prospective, randomized study of erythropoietin and i. v. iron in patients with CHF Sq epo twice a week NYHA Class III or IV LVEF < 40% Hgb 10 - 11. 5 Randomized 32 patients i. v. iron sucrose weekly Continue standard therapy Silverberg DS, Wexler D, et al. J Am Coll Cardiol 2001; 37: 1775 - 80

Prospective, randomized study of erythropoietin and i. v. iron in patients with CHF After 8 months: epo and i. v. iron observation NYHA class + 48% - 11% LVEF +5% -5% Days in hospital - 79% + 28% Hgb 10. 3 12. 9 10. 8 Ferritin 221 366 264 283 1. 7 1. 4 1. 8 Creatinine Silverberg DS, Wexler D, et al. J Am Coll Cardiol 2001; 37: 1775 - 80

Anemia of chronic disease In IBD study and in CHF study response to treatment was not predicted by: serum erythropoietin serum iron ferritin

Effectiveness of treatment with erythropoietin Goodnough, Skikne, Brugnara. Blood, 2000; 96: 823 - 833

Safety of intravenous iron Sodium ferric gluconate in sucrose (Ferrlecit) Available in Europe > 30 years 2. 7 x 106 doses/year in Germany + Italy in 1995 Iron dextran (Imferon until 1992, In. Fed since 1992) 3 x 106 doses/year in US in 1996 Faich, Strobos. Am J Kidney Dis 1999: 33(3): 464 -70

Safety of intravenous iron Reported severe adverse reactions (1976 - 1996): SFGS 3. 3 severe allergic reactions/106 doses, no fatalities ID 8. 7 severe allergic reactions/106 doses, 31 fatalities Faich, Strobos. Am J Kidney Dis 1999: 33(3): 464 -70

Safety of intravenous iron Other theoretical risks: iron overload sepsis accleration of athersclerosis Faich, Strobos. Am J Kidney Dis 1999: 33(3): 464 -70

Medicare warning : ( Recombinant human erythropoietin is approved only for treatment of anemia caused by renal failure or by cancer treatment and for certain hematologic malignancies. Sodium ferric gluconate in sucrose is approved only for treatment of anemia in patients on hemodialysis and for patients who have had a severe reaction to iron dextran.
- Slides: 41